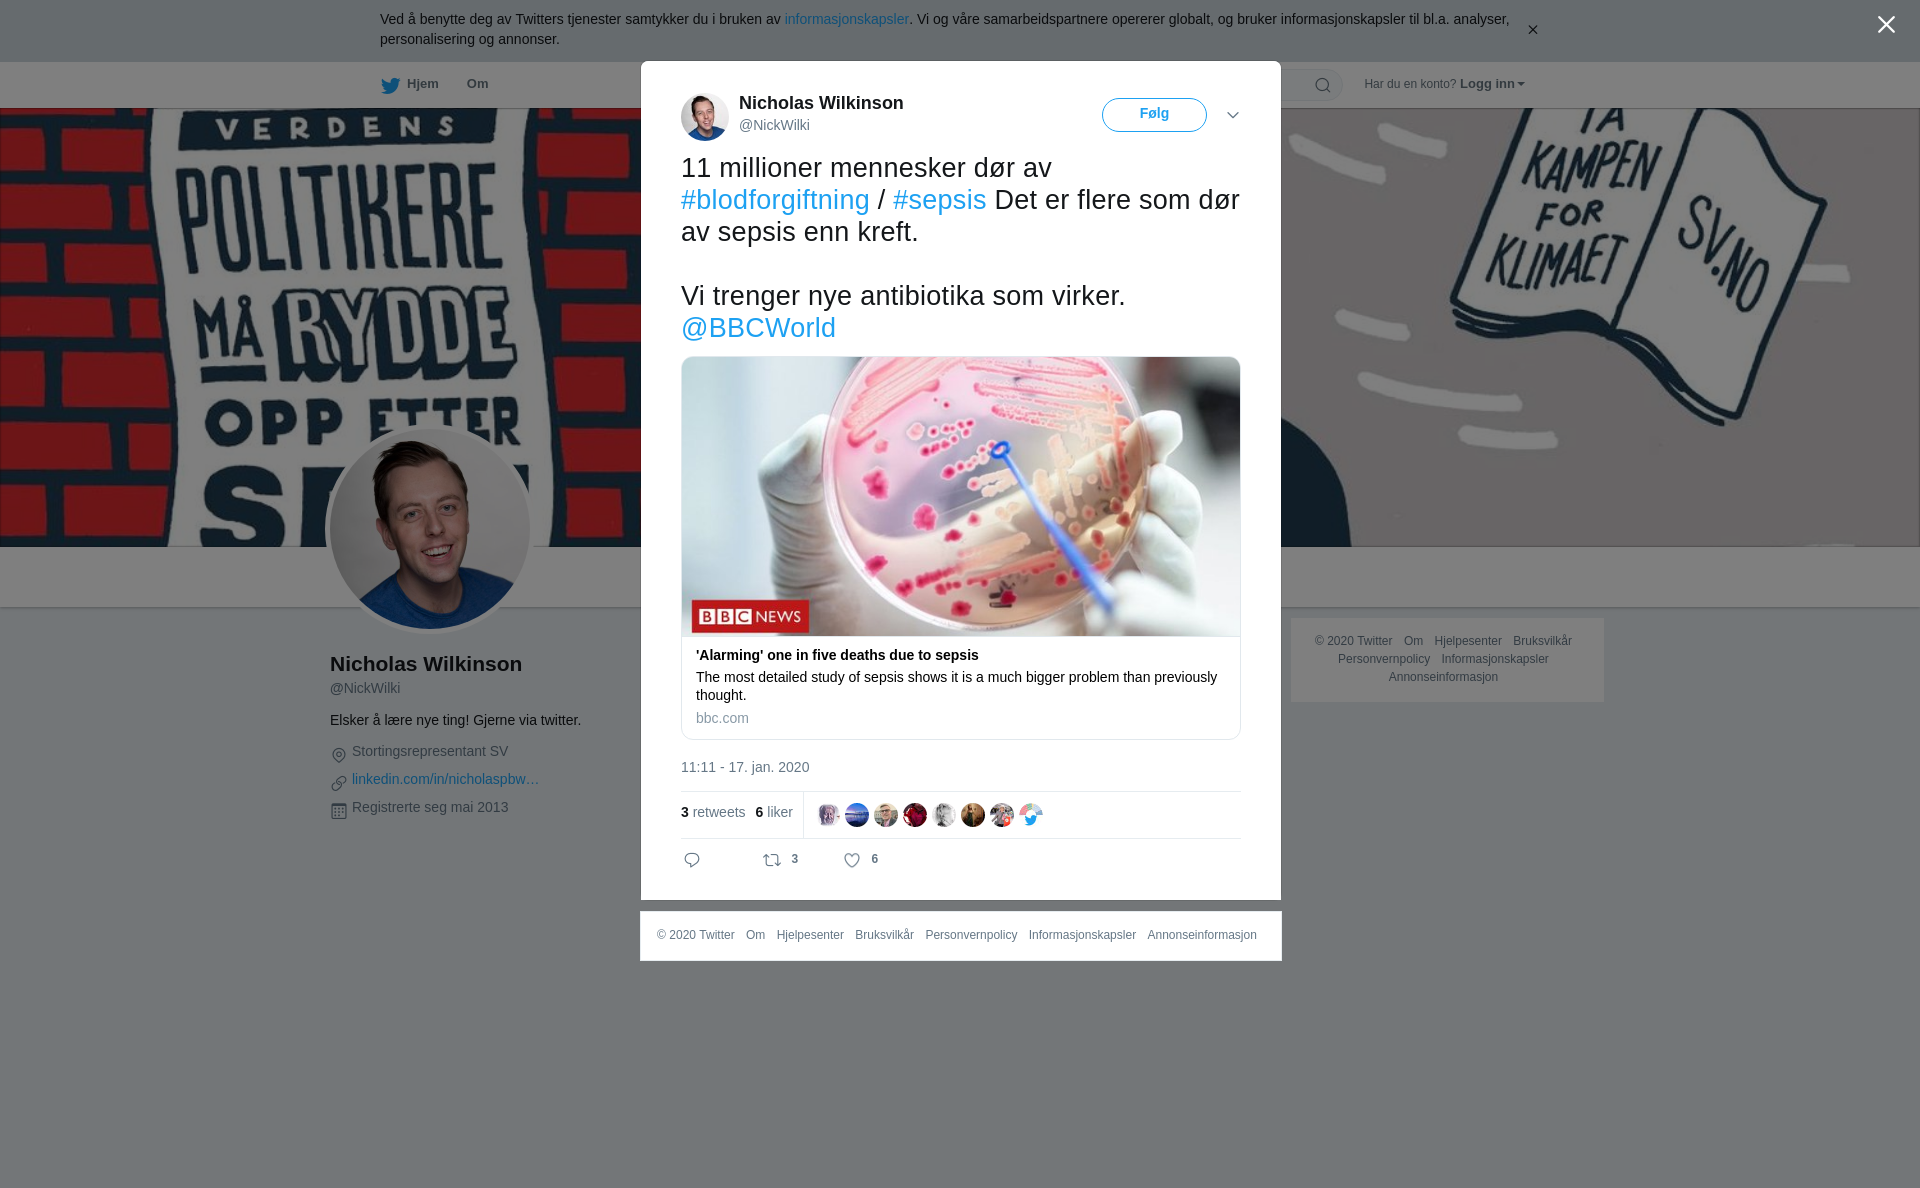

Person / Aktør:

Innlegg:
RT @NickWilki: 11 millioner mennesker dør av #blodforgiftning / #sepsis Det er flere som dør av sepsis enn kreft.
Vi trenger nye antibiot…
Emneknagger:
Postet:
2020-01-18 07:02:28